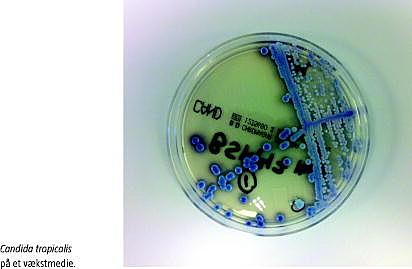

Siden begyndelsen af 1990'erne er der observeret en kontinuerlig stigning i antallet af candidæmitilfælde i Danmark. Tidligere var det dominerende patogen Candida albicans , men gennem de senere år synes andelen af non- albicans -arter med nedsat følsomhed eller resistens for fluconazol at være stigende [1, 2]. Invasiv candidiasis er en hyppig nosokomiel infektion med betydelig negativ indvirkning på morbiditet og mortalitet [1-4]. Vi ønsker med nedenstående sygehistorie at henlede opmærksomheden på diagnostiske og behandlingsmæssige udfordringer hos patienter, der er i risiko for at få eller har manifest invasiv candidiasis.
SYGEHISTORIE
En ikke tidligere hospitaliseret 76-årig mand med dysreguleret type 2-diabetes blev indlagt akut med svær sepsis. Inden initiering af empirisk antibiotisk behandling i form af meropenem og moxifloxacin givet intravenøst blev der taget blod og urin fra til dyrkning og resistensbestemmelse. Patienten blev overflyttet til intensivafsnit og intuberet på grund af respiratorisk og cirkulatorisk instabilitet.
På andendagen indløb der positivt svar fra blod- og urindyrkningerne, hvor der var fundet Escherichia coli , og den antibiotiske behandling blev ændret til monoterapi med ceftriaxon givet intravenøst. Patienten fik svær nyreinsufficiens, og man påbegyndte hæmodiafiltrationsbehandling. Efter et initialt godt klinisk og paraklinisk respons på den antibiotiske behandling fik han to uger inde i sygdomsforløbet feber samt forhøjede infektionstal, og almentilstanden forværredes, hvorfor der blev foretaget en omfattende fokusudredning.
Ved gentagne dyrkninger blev der påvist fluconazolsensitive Candida tropicalis i blod og trakealsekret, på arteriekateter, på centralt venekateter, på næse- og analslimhinderne og i fæces, hvorfor patienten blev behandlet med fluconazol givet intravenøst. Efter 11 dages behandling med fluconazol påviste man i trakealsekretet og på næseslimhinderne Candida krusei, der er resistent for fluconazol, men fuldt følsom for caspofungin og amphotericin B. På grund af højfebrilia og stigende inflammationsparametre uden anden oplagt årsag blev den antimykotiske behandling ændret til caspofungin givet intravenøst. Godt en uge senere påviste man på næseslimhinderne C andida parapsilosis , som ikke blev resistensbestemt. Samtidig påviste man Aspergillus -galactomannan-antigen og Aspergillus -antistof i blodet, hvilket er tegn på mulig akut invasiv infektion med skimmelsvampen Aspergillus . På grund af patientens vedvarende febrilia og forhøjede inflammationsparametre blev behandlingen suppleret med voriconazol givet intravenøst. Patienten blev behandlet med caspofungin og voriconazol i henholdsvis 30 og 21 dage - de sidste 21 dage som kombinationsbehandling. Øvrige mikrobiologiske fund fremgår af Tabel 1 .
Patientens tilstand bedredes, og efter otte ugers indlæggelse på intensivafsnit kunne han flyttes til stamafdelingen. Før seponering af antimykotika blev der foretaget undersøgelse af en øjenlæge, der ikke fandt tegn til endoftalmitis.
DISKUSSION
Tegn på infektion sekundært til i øvrigt relevant antibiotisk behandling bør føre til fokusudredning, som i denne sygehistorie indbefattede mikrobiologiske undersøgelser af blod, urin, fæces, trakealsekret og cerebrospinalvæske samt dyrkning af spidser på fjernede dræn og intravaskulære katetre og transøsofageal ekkokardiografi samt computertomografi af cerebrum, thorax, abdomen og bækken.
Der er bred enighed om, at empirisk antimykotisk behandling af patienter på intensivafsnit er indiceret under visse omstændigheder. De vigtigste risikofaktorer for invasiv candidiasis vurderes at være graden af svampekolonisation, større abdominalkirurgi og positive dyrkningssvar fra intravaskulært brugte kateterspidser. Længerevarende indlæggelse på intensivafsnit, langvarig bredspektret antibiotikabehandling, tilstedeværelse af centrale intravaskulære katetre og hæmodialyse eller hæmofiltration vurderes at være mindre betydende risikofaktorer [5].
Infectious Diseases Society of America (IDSA) anbefaler, at feber uden kendt årsag hos kritisk syge patienter, der har risikofaktorer for invasiv candidiasis, bør føre til overvejelser om initiering af empirisk antimykotisk behandling [4]. IDSA anbefaler følgende behandlingsstrategi ved påvist candidæmi eller sandsynlig invasiv candidiasis hos nonneutropene patienter [4]: 1) fluconazol til mindre kritisk syge patienter, der ikke for nylig har fået azolbehandling, og 2) echinocandiner til moderat til svært kritisk syge patienter eller patienter, der for nylig har fået azolbehandling.
Med fokus på invasiv candidiasis beskriver vi denne sygehistorie for at illustrere diagnostiske og terapeutiske overvejelser ved infektionstegn, der er sekundære til relevant behandling.
src="/LF/images_ufl/ufl_bla.gif">
Kim Hovgaard Maack , Hjertemedicinsk Afdeling B, Aarhus Universitetshospital, Skejby, Brendstrupgårdsvej 100, 8200 Aarhus N.
E-mail: kim.maack@hotmail.com
ANTAGET: 14. februar 2012
FØRST PÅ NETTET: 9. april 2012
INTERESSEKONFLIKTER: Forfatternes ICMJE-formularer er tilgængelige sammen med artiklen på Ugeskriftet.dk
- Arendrup MC, Fuursted K, Gahrn-Hansen B et al. Semi-national surveillance of fungaemia in Denmark 2004-2006: inc reasing incidence of fungaemia and numbers of isolates with reduced azole susceptibility. Clin Microbiol Infect 2008;14:487-94.
- Hollenbach E. Invasive candidiasis in the ICU: evidence based and on the edge of evidence. Mycoses 2008;51(suppl 2):25-45.
- Pappas PG, Rex JH, Lee J et al. A prospective observational study of candidemia: epidemiology, therapy, and influences on mortality in hospitalized adult and pediatric patients. Clini Infect Dis 2003;37:634-43.
- Pappas PG, Kaufmann CA, Andes D et al. Clinical Practice Guidelines for the Management of Candidiasis: 2009 update by the Infectious Diseases Society of America. Clin Infect Dis 2009;48:503-35.
- Kullberg BJ, Verweij PE, Akova M et al. European expert opinion on the management of invasive candidiasis in adults. Clin Microbiol Infect 2011;17(suppl 5):1-12.
<ol class="Litt-list">
<li>Arendrup MC, Fuursted K, Gahrn-Hansen B et al. Semi-national surveillance of fungaemia in Denmark 2004-2006: increasing incidence of fungaemia and numbers of isolates with reduced azole susceptibility. Clin Microbiol Infect 2008;14:487-94.</li>
<li>Hollenbach E. Invasive candidiasis in the ICU: evidence based and on the edge of evidence. Mycoses 2008;51(suppl 2):25-45.</li>
<li>Pappas PG, Rex JH, Lee J et al. A prospective observational study of candidemia: epidemiology, therapy, and influences on mortality in hospitalized adult and pediatric patients. Clini Infect Dis 2003;37:634-43.</li>
<li>Pappas PG, Kaufmann CA, Andes D et al. Clinical Practice Guidelines for the Management of Candidiasis: 2009 update by the Infectious Diseases Society of America. Clin Infect Dis 2009;48:503-35.</li>
<li>Kullberg BJ, Verweij PE, Akova M et al. European expert opinion on the management of invasive candidiasis in adults. Clin Microbiol Infect 2011;17(suppl 5):1-12.</li>
</ol>
Summary Fungal infection secondary to treatment of Escherichia coli in a critically ill patient Ugeskr Læger 2012;174(35):1997-1998 The incidence of nosocomial fungal infections has increased over the past 20 years. Candida albicans is the most commonly involved pathogen. Concurrently, the number of non- albicans species with decreased susceptibility to commonly used antifungal agents has increased significantly. Invasive candidiasis is associated with significant morbidity and mortality. We present a case of unusually massive infection with a number of different Candida species , which caused severe prolonged infection in a critically ill patient.